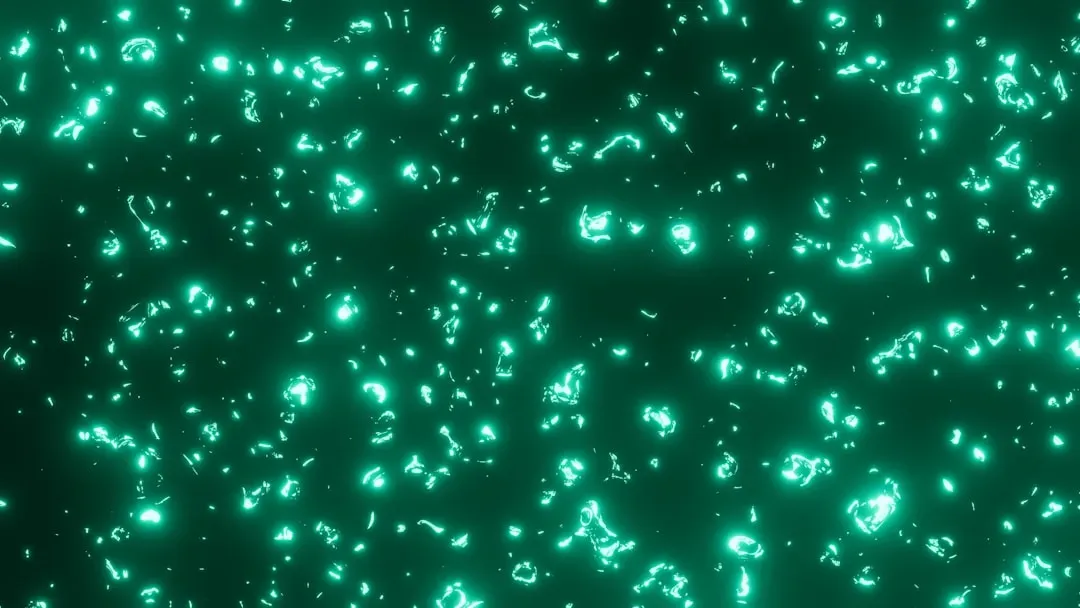
7. Phosphorus: The Element That Lit The Dark And Illuminated Its Own Dangers (Image Credits: Unsplash)

If you think chemistry is just about boring formulas on a whiteboard, these elements might change your mind. Some of them shatter what we thought was possible in nature: metals that melt in your hand, gases that carry life, and solids that explode from a tiny scratch.
When I first learned real details about a few of these, it honestly felt closer to science fiction than a school subject. Let’s walk through seven elements that behave so strangely, they almost feel like they’re breaking the rules of reality.
1. Gallium: The Metal That Melts In Your Hand

Imagine picking up a shiny, silvery “piece of metal” and feeling it slowly turn to liquid in your palm. That’s gallium. Its melting point is just above normal room temperature, so the warmth of your hand is enough to melt it into a puddle, yet it’s still a solid metal on your desk. It doesn’t corrode easily in air, so you can play with it, melt it, and watch it freeze again without it turning dull or flaky.
Gallium is used in LEDs, lasers, and high-speed electronics, quietly enabling the screens and communication tech we use every day. It also forms strange mirror-like alloys that can wet glass and other materials in unusual ways. The first time you see solid gallium “bleed” into a shiny liquid, it feels oddly emotional, like watching something alive change states. It’s a reminder that even something as “fixed” as a metal can behave in surprisingly fluid ways.
2. Helium: The Gas That Defies Gravity And Freezes Into Weird Quantum States

Helium is famous for party balloons and squeaky voices, but that’s the most boring thing about it. It’s so light that on Earth it literally escapes into space, which is why we treat it as a limited resource. At extremely low temperatures, helium refuses to freeze under normal pressure, and instead turns into a superfluid that climbs walls and leaks through cracks that no ordinary liquid can pass.
In this superfluid state, helium can flow without friction, spin in strange vortex patterns, and behave in ways that feel almost like a physics magic trick. Helium is also absolutely critical for cooling powerful magnets in MRI machines and some quantum computers, holding together technologies that probe into our bodies and into the nature of information itself. It’s a bit wild that the same element you put in a birthday balloon is quietly supporting the frontiers of modern science. It’s like discovering your goofy cousin is also a world-class surgeon.
3. Carbon: The Shape-Shifter That Builds Life, Diamonds, And Futuristic Materials

Carbon is so common that it’s easy to forget how outrageous it actually is. With the same basic element, you can get soft, black graphite that rubs off on your fingers and ultra-hard, transparent diamond that can cut through almost anything. The only real difference is how the atoms are connected. It’s as if using the same set of Lego pieces, you could build both a pillow and a bulletproof wall.
Beyond graphite and diamond, carbon forms graphene, a single-atom-thick sheet that’s incredibly strong, flexible, and electrically conductive. It’s being explored for faster electronics, better batteries, and ultra-light materials. And of course, carbon is the backbone of life: from your DNA and proteins to the food you eat and the fuel you burn, carbon is everywhere. There’s something strangely poetic about the fact that the same element makes your brain work, your smartphone battery run, and the gemstones in an engagement ring sparkle.
4. Mercury: The Shimmering Liquid Metal We Had To Learn To Fear

Mercury is the only metal that’s a liquid at room temperature, forming a dense, silvery pool that almost looks alive. For centuries it fascinated people, showing up in thermometers, barometers, and even alchemy, where it symbolized transformation and fluidity. Watching a blob of mercury split apart and fuse back together is mesmerizing, like seeing a metallic raindrop with a mind of its own.
But mercury is also deeply toxic, and we’ve slowly realized just how dangerous long-term exposure can be to the brain and nervous system. That’s why it’s being phased out of many devices, and spills are treated very seriously. In a way, mercury is a cautionary tale about being dazzled by beauty and novelty without thinking about consequences. It’s a reminder that nature doesn’t care if something looks magical; it can be stunning and harmful at the same time.
5. Fluorine: The Most Aggressive Element You Never Want To Meet Alone

Fluorine gas is pale yellow, but don’t let that soft color fool you: it’s the most reactive element on the periodic table. It can attack glass, metals, and many compounds that other chemicals barely notice, releasing intense heat and energy. Chemists need special equipment and serious precautions just to handle it safely, and even then, it commands a certain level of nervous respect.
Yet when fluorine is tamed and bonded in controlled ways, it becomes incredibly useful. It appears in some pharmaceuticals, non-stick coatings, and refrigerants, giving materials surprising stability or slipperiness. The fluoride in toothpaste is a much milder form that helps protect our teeth from decay. There’s something almost unsettling about how an element that can behave like a chemical monster in pure form becomes a helpful partner when carefully bound, like training a wild animal just enough to live around humans.
6. Uranium: The Heavy Metal That Can Power Cities Or Devastate Them

Uranium is a heavy, silvery metal that doesn’t look particularly dramatic at first glance, but its nucleus hides an enormous amount of energy. When split in a controlled chain reaction, uranium can generate huge amounts of electricity in nuclear power plants with almost no direct carbon emissions. A small amount of uranium fuel can replace mountains of coal, which is both impressive and a little frightening.
The same physics behind this power also underlies nuclear weapons, and that dual nature makes uranium one of the most controversial elements on Earth. We rely on it for low-carbon energy in many countries, while also wrestling with questions of safety, radioactive waste, and global security. Uranium forces us to confront a hard truth: sometimes the tools with the greatest potential benefit also carry the most severe risks, and there’s no way to fully separate one from the other.
7. Phosphorus: The Element That Lit The Dark And Illuminated Its Own Dangers
Phosphorus literally helped humans bring light into the dark. Early forms of matches used white phosphorus, which could ignite with friction and made fire-starting incredibly easy compared to older methods. The element itself can glow faintly in the dark under some conditions, which is why its name comes from a word meaning “light-bearer.” It must have seemed almost supernatural when it was first isolated.
But that convenience came at a terrible cost: workers in match factories suffered severe health problems, including horrific jaw damage from chronic exposure to white phosphorus. Eventually, safer forms and alternatives were developed, and white phosphorus was restricted in many uses. At the same time, phosphorus is completely essential to life, embedded in DNA, cell membranes, and the energy-carrying molecules that keep our cells running. It’s strangely moving that the same element sits both at the heart of our biology and in the painful history of industrial harm, a reminder that progress often comes with a shadow.
These seven elements show that the periodic table isn’t just a chart on a classroom wall; it’s a collection of characters with wildly different personalities. Some melt in your hand, some carry life, some glow, some can power entire cities, and others demand serious respect just to sit in the same room with them. They’re a mix of beauty, danger, usefulness, and mystery, all hiding in plain sight as “just” atoms with different numbers of protons.
Once you start to see elements this way, chemistry stops feeling like memorization and starts feeling more like meeting the cast of a very intense, very real drama. The world around you becomes less flat and more alive, full of hidden abilities and strange behaviors waiting just below the surface. Which element surprised you the most?




